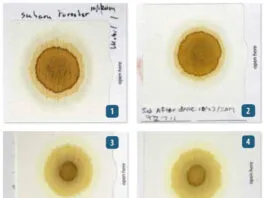
DIY Engine Oil Tests Blotter test patterns reveal engine condition: clean oil shows defined rings, while coolant contamination shrinks the center circle by clogging pores. Fuel dilution may not create obvious visual changes—in some cases, smell is the primary indicator—making successive comparisons essential for spotting subtle shifts in engine health. See more detailed info about these tests at the end of the article. (Photo/ Drew Frye)

How to Create a Bullet-Proof VHF/SSB Backup
In this short article I want to chat about ideas for making the radio bombproof in an emergency. I haven’t “invented” any of these...
Fuel Lift Pump: Easy DIY Diesel Fuel System Diagnostic and Repair
As with all things in life, everything goes well until it doesn’t. It is an inevitable truth that something will go wrong eventually and...
Ensuring Safe Shorepower
Power pedestals are handy and safe when they match the power requirements of the boat. Thirty amps for a 30-amp boat. Fifty amps for...
Sinking? Check Your Stuffing Box
Sometimes as a sailor you are learning to run before you can walk or even crawl. If the auto bilge pump isn’t working, maybe...
The Rain Catcher’s Guide
An efficient, clean rainwater catchment isn't just for cruisers venturing into remote areas. While biologically safe, many areas of the U.S. are served by well water that is not chlorinated, high in sulfate that makes it prone to going bad. When stored in the absence of oxygen, the sulfate becomes the preferred oxygen source for microorganisms and hydrogen sulfide is the byproduct. Only .05 parts per million (ppm) sulfide is required to make water distasteful. Even if the water at your next marina is fresh and sweet, filling from an unfamiliar source is always a roll of the dice.
How to Change Your Engine Mounts
It is always discomforting when you know, and actually feel, that something is not quite right. For a little while now, while navigating under...
Keeping Water Clean and Fresh
In the first part of our three-part series covering onboard water quality, we discussed protecting the tank with basic filtration and securing the tank vent. Further action is required, however, as the tank and its contents will always be far from sterile. Municipal water is filtered to remove turbidity, disinfected (typically with chlorine, ozone, or ultraviolet light), filtered once more (often very fine filtration to remove cryptosporidium cysts, which resist disinfection), and disinfected once more (with chlorine or chloramine) to protect the water while its in the distribution system. However, since we are storing the water on our boats, this process of secondary disinfection becomes our responsibility. So what are the options for treating water that is already in an onboard tank?
How to Do an Engine Compression Test
An engine compression test is an important diagnostic test that any boat owner can do with equipment that costs about $50. You can also...
Dinghy Outboard Diagnostics
In my past life I worked in the automotive industry for over 20 years. In that time, I realized that the hard part about...
Spring Season Engine Start-Up for Winterized Engines
Two things, as they say, are certain in life: death and taxes. Perhaps a third would be that fuel cost will inevitably keep rising....